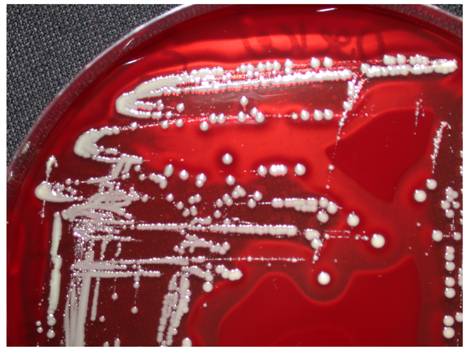
Int J Med Sci Image

Impact Factor ISSN: 1449-1907
Int J Med Sci 2009; 6(5):234-240. doi:10.7150/ijms.6.234 This issue Cite
Review
Pathogenic organisms in hip joint infections
Institute of Medical Microbiology and Hygiene, University of Saarland Hospital, Homburg (GER)
Received 2009-8-10; Accepted 2009-8-28; Published 2009-9-2
Abstract
Infections of the hip joint are usually of bacterial etiology. Only rarely, an infectious arthritis is caused in this localization by viruses or fungi. Native joint infections of the hip are less common than infections after implantation of prosthetic devices. Difficulties in prosthetic joint infections are, (I) a higher age of patients, and, thus an associated presence of other medical risk factors, (II) often long courses of treatment regimes depending on the bacterium and its antibiotic resistance, (III) an increased mortality, and (IV) a high economic burden for removal and reimplantation of an infected prosthetic device. The pathogenic mechanisms responsible for articular infections are well studied only for some bacteria, e.g. Staphylococcus aureus, while others are only partially understood. Important known bacterial properties and microbiological characteristics of infection are the bacterial adhesion on the native joint or prosthetic material, the bacterial biofilm formation, the development of small colony variants (SCV) as sessile bacterial types and the increasing resistance to antibiotics.
Keywords: arthritis, bacteria, diagnosis, prosthesis, therapy
Infectious arthritis
The infection of a joint can occur in different ways, (I) via injection or during joint operation through direct colonization, (II) by direct contact with a neighboring infected site, or (III) by haematogenous or lymphogenous seed of the pathogen. Another classification of bacterial arthritis distinguishes acute, chronic and reactive forms, which differ in their type of joint infection and their triggering bacteria. Reactive arthritis is a postinfectious complication with no need of presence for viable pathogens in the joint. While reactive arthritis often simultaneously affect several joints, the presence of polyarthritic types of non reactive arthritis occur infrequently and then mostly as a result of several bacteriaemic phases.
Among joint infections, the hip is the second most frequent localization after the knee joint. Basically, there are no differences in the bacterial spectrum between hip joint infections and those of other large joints. Hip joint infections, however, are aggravated by the fact that they can exist over a long time with only poor symptoms. An increased rate of infection occurs in the pre-damaged joint and is also associated with particular predispositions of the patients (Table 1) [1,2,3]. In particular, a joint prosthesis is a high risk predisposition for an infection. Perioperatively the initial bacterial entry into the joints may occur. On the other hand the implanted foreign material causes in addition to the severe joint disease present an additional reduction in local resistance, which facilitates haematogenous infections. The prosthetic materials are also additional binding sites for various bacteria, and act as a starting point for prosthetic infections. Thus, in addition to the local conditions, the bacterial properties and their specific pathogenity have to be considered for understanding the whole mechanism of infection. Basically, a too late or not sufficiently cured joint infection can cause trophic and functional limitations or can even be the starting point of a progressive infection spreading in continuity, lymphogenic or haematogenic. In general, the detection and treatment of acute infectious arthritis is an acute emerging situation, in which a delay may progress to further septic inflammation [2].
Predisposing factors

Bacteria responsible for (hip) joint infections
Some bacteria have preferences for certain infection routes and patterns. Infections not related to injuries or medical interventions (e.g. intraarticular puncture, joint replacement) are mostly resulting from often physiologic bacteriaemic periods. The most frequently detected pathogens of joint infections are staphylococci. Staphylococcus aureus has dominance in acute purulent arthritis while coagulase-negative staphylococci can be found mainly in periprosthetic infections and after diagnostic arthroscopies. Other gram-positive bacteria as causative agents for hip joint infections are streptococci, especially Streptococcus pyogenes, Enterococcus faecalis and Corynebacteria species.
A large number of different gram-negative rods act as infectious agents on joints. The group of enterobacteria contains a broad spectrum of pathogens. Salmonella enterica, Shigella species, and Yersinia species are classically described as pathogens for purulent and reactive forms of arthritis. Pseudomonas aeruginosa can be found more often in predisposed patients (e.g. diabetics). In otherwise healthy people it is associated with iatrogenic modes of infection during diagnostic procedures. Campylobacter species, however, are classic agents of reactive arthritis, as well as the obligate intracellular bacteria Chlamydia trachomatis, Mycoplasma pneumoniae, and Ureaplasma urealyticum. From the spirochaetales only Borrelia burgdorferi sensu lato is relevant. Less commonly identified organisms for joint infections often accompanied with osteitis or osteomyelitis are Brucella species and Mycobacterium tuberculosis. Anaerobes, such as Bacteroides fragilis, are rarely found and are usually part of a polymicrobial infection. An overview is shown in Table 2.
Bacteria responsible for (hip) joint infections

Pathogenesis
If bacteria reach into the joint they can bind to a large number of different binding molecules. Especially fibrinogen, extracellular matrix proteins and glycosaminoglycans, including fibronectin and laminin, are components of the blood plasma, the bacteria use adhesion to [4,5]. A large number of bacteria specific receptors (adhesins) and adhesion factors have been described. The intra- and interspecific variation of the expression of these bacterial pathogenity factors can be correlated with the inherent bacterial virulence [6,7]. In this large microbiological and infectiological field a lot of research is done for Staphylococcus aureus. This is also substantiated by the production of various cytotoxins and the presence of highly effective signaling mechanisms [3]. Another bacterial feature is the formation of a biofilm, a polymeric matrix of saccharides, primarily described in the colonization of foreign material. Biofilm production as an important mechanism of pathogenesis can be detected for S. aureus, coagulase-negative staphylococci, Pseudomonas aeruginosa and other bacteria (Figure 1). It was also shown that bacteria inside the biofilm have an increased resistance to the local host defenses and to antibiotics [8]. Additionally, through the conversion into so-called small colony variants (Figure 2) additional modifications of bacterial cells develop [9], while significantly reducing treatment efficiency and triggering chronic processes. The formation of an inflammatory response, with the local generation of cytokines and reactive bacterial and host specific metabolic products leads to a joint injury, not seldom to irreversible destruction. Thus, effective therapy strategies must combine calculated antibiotic regimes with local surgical interventions.
(left) Raster electron microscopy of Staphylococcus aureus from broth culture; (right) Staphylococcus aureus biofilm. Images from S. Sailer und I. Chatterjee, Homburg/Saar.

Staphylococcus aureus as normal phenotype and as small colony variant (SCV). Note the different size and hemolysis (identical molecular pattern).

Joint replacement surgery increases the risk of infections due to intraoperative bacterial wound contamination, leading to an early onset of the typical symptoms. The material of the joint prosthesis is also covered by host proteins such as fibrinogen and fibronectin, which in turn facilitates bacterial colonization, leading to a delayed type of PJI. The foreign material allows not only a surface colonization; it is also responsible for a reduction of the local defense mechanisms. Among others, it leads to an apoptosis of phagocytes surrounding the joint prosthesis; a mechanism described as frustrane phagocytosis [10].
Reactive arthritis (RA), however, is aseptic and usually not erosive. It results from a distant infection (usually urethritis or enteritis). Often the reactive arthritis is disseminated and involves multiple joints. The immunological mechanism of the frequent association with HLA-B27 is not yet fully understood. Using immunological and molecular biological procedures bacterial antigens can be detected in synovial fluid and synovial membrane [11]. Although in some studies viable bacteria could be detected [12], in an overview of research results it can be concluded that bacterial antigenetic material or antigen-antibody complexes are haematogenous deposited in the joint. This triggers a local inflammatory immune reaction, even without local bacterial proliferation [3,13].
Microbiologic procedures in joint infections
A differentiation of arthritis is practicable by examination of typical laboratory medicine and microbiology characteristics in joint fluid. In addition to the macroscopic parameters (e.g. color, viscosity) the gram stain is the fastest test, giving a hint to the triggering agent. Beside the inflammatory parameters, such as erythrocyte sedimentation rate (ESR), C-reactive protein (CRP), and white blood cell count, which are nonspecific and do not provide location-related information, the synovial fluid leukocyte count is a simple, rapid and accurate test. The changes in acute joint infections are often more pronounced. For a targeted therapy the microbiologic examination is the most important step [14]. Thus, joint fluid or intraarticular tissue must be obtained before antibiotic therapy is started. Swabs, also from intraoperative sites should not be sent into the laboratory due to the small quantity of carried material. Also swabs or tissue from superficial wounds or fistula often show the growth of skin flora and not the relevant bacteria. Only isolation of S. aureus from sinus tracts is predictive of the causative pathogen [15]. Especially in PJI an operational approach is useful to obtain and examine several materials. Although molecular techniques have a high value as a diagnostic procedure, only bacterial cultures can complete the diagnostic testing by antibiograms. The incubation time of the bacterial culture should last 7 days. Slow-growing bacteria as a pathogen in question, the presence of bacteria modificated by antibiotic pretreatment, SCV or biofilm production need an extended culture period [16]. Both, joint defect formation and chronification, if NJI, are not treated quickly and efficiently, and increasing mortality, high economic burden for removal of infected joint prosthesis and implant renewing [17] always require the increased effort in sampling and microbiological analysis.
Infection serology
In reactive arthritis the cultural detection of pathogens is often not possible. This makes serological analysis to a method principally necessary to detect antibodies against the causing bacteria. The antibody detection has a great diagnostic value also due to the reduced sensitivity of bacterial culture in joint infections caused by Borrelia or Brucella. For a medically and economically adequate evaluation in serologic diagnosis the sensitivity and specificity of the various methods must be considered. An overview of the bacteria that most commonly trigger reactive arthritis is listed in Table 3.
Serodiagnosis of common bacterial agents for postinfectious arthritis

Antibiotic therapy
The therapeutic approach has to be selected in accordance with the mode of infection (NJI, PJI, RA), the expected or found pathogens, and their resistance. It should be remembered that the slowed growth of bacteria in a biofilm on surfaces of joint prosthesis may additionally reinforces antibiotic resistance [18,19]. Responsible for such an increase against antibacterial substances are changes in cell wall synthesis, which limits the effect of beta-lactam antibiotics and glycopeptides, and the occurrence of bacterial variants with modifications of other metabolic activities, with implications for the action of quinolones, aminoglycosides, and tetracyclines. In principle, the spectrum of available antibiotics is limited by the specific pharmacokinetic requirements in the treatment of joint infections. This applies particularly to chronic infections and prosthesis infections. For an overview of common substances and therapeutic regimes, see Table 4.
Antibiotics for therapy of infectious arthritis (all given dosages are for healthy adults of 70 kg with normal liver and kidney function)
Acute native joint infectious arthritis
Essential for sufficient treatment of acute septic arthritis is the fast and aggressive therapy with the combined application of antimicrobial medication and joint lavage. Regarding the duration of treatment, there are no controlled studies. The recommendations vary for native joint infections between 2-3 weeks and 6 weeks in the presence of accompanied osteomyelitis and / or if the clinical response is only moderate. For initial therapy in the presence of clustered gram positive cocci in microscopic examination and, therefore, most likely an infection with S. aureus is the intravenous therapy with a penicillinase-resistant penicillin. For gram positive chainlike cocci, thus highly suspicious for a streptococcal infection, penicillin G is empirically given. Most of the gram negative rods have their effective therapy initially with a quinolone or a second or third generation cephalosporin. In the case of a negative gram stain, first or second generation cephalosporines (e.g. Cefazolin, Cefuroxime), possibly in combination with an anti-staphylococcal penicillin (e.g. Flucloxacillin), are a calculated approach. If, after culture results and / or availability of antibiograms the first selected antibiotic regime has to be adjusted, then it has to be carried out immediately.
Prosthetic Joint Infection
In the treatment of PJI virtually every conceivable form was tried out, antibiotics alone or in combination with debridement and intraarticular lavage, the ex- and reimplantation of the prosthesis in one or two stages, the arthrodesis or as a last option the amputation. In all, however, the prolonged antibiotic therapy is a crucial factor.
An algorithm has been described, suggesting the surgical management as a function of the time period from surgical intervention till onset of PJI, the type of infection, the implant and soft tissue situation and existing co-morbidities [20]. From the experience in antibiotic therapy of bone and joint infections the requirements for an "ideal drug" may be formulated. Beneficial characteristics are bactericidal action, effective bone and tissue concentrations, opportunity for oral sequential therapy, and no adverse side effects. Even if these aspects should be included in the selection of the drug of choice, the finding is, however, that (I) for many of these parameters (e.g. antibiotic penetration into the bone) no reliable experimental data are available, (II) studies correlating these ideal characteristics with the clinical outcome are largely lacking, (III) there is currently no single substance, which fully corresponds to all requirements.
It was shown that the sole antibiotic therapy for early-onset PJI may be curative. For infections with staphylococci particularly antibiotic combinations with Rifampicin possesses high cure rates. A surgical intervention must be always combined with a sufficient antibiotic therapy. Also in this constellation Rifampicin plays in staphylococcal infections a prominent role [21]. For infections caused by MRSA and MRSE Teicoplanin and Vancomycin are used. Extending this repertoire with newer antibiotics, especially Linezolid, Daptomycin and Tigecyclin were introduced for PJI therapy. A valid rating for the newest (lipo)glycopeptides Oritavancin, Dalbavancin, Telavancin, and for the cephalosporins Ceftobiprol and Ceftarolin in treatment of methicillin-resistant staphylococci is currently not possible.
Antibiotic prophylaxis
The perioperative antibiotic prophylaxis is one of the procedures, which clearly demonstrates the reduction of infection rate after joint surgery [22,23]. Important is the application time before operation, about 30-60 min before cutting time. The most widely used antibiotics in orthopedic surgery are cephalosporins of the first or second generation, like Cefazolin or Cefuroxime. Alternatives in patients with beta-lactam allergy are Vancomycin or Clindamycin. In hospitals with high prevalence of MRSA Vancomycin is also used.
Haematogenous infections of the joint prosthesis may be due to transient bacteremia. Thus, antibiotic prophylaxis during dental procedures or genitourinary tract and gastrointestinal tract interventions are useful in order to prevent late-onset prosthetic infection [24].
Discussion
There are only a few interfaces in medicine of such high importance like the interaction between surgeons, physicians and microbiologists in the preanalytical, analytical and postanalytical phases in the diagnosis and treatment of joint infections. This process generally requires a coordination and optimization by all parties. Conclusions must be made for the samples to be investigated, their required numbers and volumes, the sample collection method, time and mode of transport, and the communication of laboratory results. Each of these items can cause a delay or failure in efficient diagnosis and therapy. An initially chosen antimicrobial therapy has to be adapted on the results of diagnostic procedures, the infectious agent detected or most probable, and the planned surgical procedure. The bacterial culture in the microbiological laboratory, especially for PJI and other infections probably due to slow-growing bacteria require an extended period of 7 to 14 days. Especially for these bacteria molecular biology procedures complete the diagnostic scheme. Finally it should be noted that the occurrences of postoperative joint infections should be combined with investigations regarding their epidemiological value (e.g. accumulations of a certain pathogen or associations with a certain type of surgery). These results have a great relevance in detection and prevention of nosocomial infections.
Abbreviations
HLA: Human leukocyte antigen; MRSA: Methicillin resistant Staphylococcus aureus; MRSE: Methicillin resistant Staphylococcus epidermidis (coagulase negative staphylococci); MSSA: Methicillin sensitive Staphylococcus aureus; MSSE: Methicillin sensitive Staphylococcus epidermidis (coagulase negative staphylococci); NJI: Native joint infection; PJI: Prosthetic joint infection; RA: Reactive arthritis; SCV: Small colony variants.
Conflict of interests
The author declared that no conflict of interest exists.
References
1. Kaandorp CJ, Krijnen P, Moens HJ, Habbema JD, van Schaardenburg D. The outcome of bacterial arthritis: a prospective community-based study. Arthritis Rheum. 1997;40:884-92
2. Kaandorp CJ, van Schaardenburg D, Krijnen P, Habbema JD, van de Laar MA. Risk factors for septic arthritis in patients with joint disease. A prospective study. Arthritis Rheum. 1995;38:1819-25
3. Shirtliff ME, Mader JT. Acute septic arthritis. Clin Microbiol Rev. 2002;15:527-44
4. Herrmann M, Vaudaux PE, Pittet D, Auckenthaler R, Lew PD, Schumacher-Perdreau F, Peters G, Waldvogel FA. Fibronectin, fibrinogen, and laminin act as mediators of adherence of clinical staphylococcal isolates to foreign material. J Infect Dis. 1988;158:693-701
5. McGavin MH, Krajewska-Pietrasik D, Rydén C, Höök M. Identification of a Staphylococcus aureus extracellular matrix-binding protein with broad specificity. Infect Immun. 1993;61:2479-85
6. Lopes JD, dos Reis M, Brentani RR. Presence of laminin receptors in Staphylococcus aureus. Science. 1985;229:275-7
7. Switalski LM, Patti JM, Butcher W, Gristina AG, Speziale P, Höök M. A collagen receptor on Staphylococcus aureus strains isolated from patients with septic arthritis mediates adhesion to cartilage. Mol Microbiol. 1993;7:99-107
8. Brause BD. Infections associated with prosthetic joints. Clin Rheum Dis. 1986;12:523-36
9. Sendi P, Rohrbach M, Graber P, Frei R, Ochsner PE, Zimmerli W. Staphylococcus aureus small colony variants in prosthetic joint infection. Clin Infect Dis. 2006;43:961-7
10. Roisman FR, Walz DT Finkelstein AE. Superoxide radical production by human leukocytes exposed to immune complexes: inhibitory action of gold compounds. Inflammation. 1983;7:355-62
11. Taylor-Robinson D, Keat A. Septic and aseptic arthritis: a continuum? Baillieres Best Pract Res Clin Rheumatol. 1999;13:179-92
12. Gérard HC, Branigan PJ, Schumacher HR Jr, Hudson AP. Synovial Chlamydia trachomatis in patients with reactive arthritis/Reiter's syndrome are viable but show aberrant gene expression. J Rheumatol. 1998;25:734-42
13. Colmegna I, Cuchacovich R, Espinoza LR. HLA-B27-Associated Reactive Arthritis: Pathogenic and Clinical Considerations. Clin Microbiol Rev. 2004;17:348-69
14. Geipel U, Herrmann M. The infected implant. Part 1: bacteriology. Orthopäde. 2004;33:1411-28
15. Atkins BL, Athanasou N, Deeks JJ, Crook DW, Simpson H, Peto TE, McLardy-Smith P, Berendt AR. Prospective evaluation of criteria for microbiological diagnosis of prosthetic-joint infection at revision arthroplasty. The OSIRIS Collaborative Study Group. J Clin Microbiol. 1998;36:2932-9
16. Schäfer P, Fink B, Sandow D, Margull A, Berger I, Frommelt L. Prolonged bacterial culture to identify late periprosthetic joint infection: a promising strategy. Clin Infect Dis. 2008;47:1403-9
17. Sculco TP. The economic impact of infected joint arthroplasty. Orthopedics. 1995;18:871-3
18. Bayston R, Wood H. Small colony variants - are they anything to do with biofilms? In: (ed.) Wimpenny J, Handley P, Gilbert P. et al. Biofilms: community interactions and control. University of Cardiff: Bioline Publications. 1997:161-5
19. Gilbert P, Allison DG. Biofilms and their resistance towards antimicrobial agents. In: (ed.) Newman HN, Wilson M. Dental Plaque. University of Cardiff: Bioline Publications. 1999:125-43
20. Zimmerli W, Ochsner PE. Management of infections associated with prosthetic joints. Infection. 2003;31:99-108
21. Zimmerli W, Widmer AF, Blatter M, Frei R, Ochsner PE. Role of rifampin for treatment of orthopedic implant-related staphylococcal infections: a randomized controlled trial. Foreign-Body Infection (FBI) Study Group. JAMA. 1998;279:1537-41
22. AlBuhairan B, Hind D, Hutchinson A. Antibiotic prophylaxis for wound infections in total joint arthroplasty: a systematic review. J Bone Joint Surg Br. 2008;90:915-9
23. Mangram AJ, Horan TC, Pearson ML, Silver LC, Jarvis WR. Guideline for prevention of surgical site infection, 1999. Hospital Infection Control Practices Advisory Committee. Infect Control Hosp Epidemiol. 1999;20:250-78
24. Esposito S, Leone S. Prosthetic joint infections: microbiology, diagnosis, management and prevention. Int J Antimicrob Agents. 2008;32:287-93
Author contact
Correspondence to: Udo Geipel, MD, Institute of Medical Microbiology and Hygiene, University of Saarland Hospital, Kirrberger Strasse, Bldg 43, 66421 Homburg, Germany. Phone: +49-6841-162-3946; Fax: +49-6841-162-3985; Email: dr.udo.geipeleu

 Global reach, higher impact
Global reach, higher impact